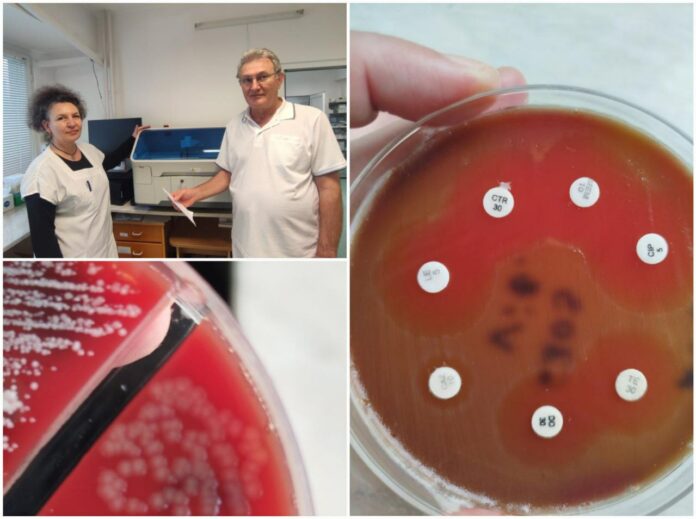
Бактерия човекоядец

Лекари от УМБАЛ-Бургас успешно спасиха живота на 61-годишна жена, заразена с изключително рядката, но опасна бактерия Вибрио вулнификус, известна като „бактерия човекоядец“. Жената, която пострадала по време на почивка на къмпинг Силистар, влязла в морето с открита рана на крака. В рамките на същия ден кракът ѝ започнал да се подува, появили се мехури и температура.
„Установихме инфекция, която веднага тръгнахме да овладяваме хирургично“, споделя д-р Тодор Шуплев, дежурен хирург. Взетата микробиологична проба бързо показала наличието на Вибрио вулнификус, разпозната от д-р Калина Цанкова, началник на Микробиологичната лаборатория.
„Тази бактерия е много характерна и лесна за разпознаване“, обяснява тя.
Месец борба и 10 операции
Жената преминала през 10 хирургични интервенции, по време на които целият екип на Втора хирургия се борел за нейния живот. Въпреки първоначалните признаци на сепсис и полиорганна недостатъчност, благодарение на навременното антибиотично и хирургично лечение, пациентката е успяла да се възстанови напълно.
„Въпреки сериозната инфекция, успяхме да избегнем ампутация, което е рядко постижение в такива случаи“, допълва д-р Шуплев.
Призив от лекарите: Не влизайте в морето с открити рани
Лекарите предупреждават, че дори малка рана може да се превърне в отворена врата за смъртоносни инфекции.
„Хората не подозират колко опасна може да бъде една раничка, особено при контакт с морска вода“, призовават те. Въпреки че инфекцията е рядка, този случай показва сериозността на бактерията, особено при хора с отслабен имунитет.
Разходите и бъдещето
Лечението на пациентката надвишило няколко пъти стойността на клиничната пътека, като само лекарствата стрували над 9000 лева.
„На всеки няколко месеца имаме по един такъв случай, който натоварва значително финансово болницата“, обясняват от Втора хирургия.
Случаят вече се подготвя за научна публикация и ще бъде представен на предстоящ медицински конгрес.
Българската история с Румен Петков: Петър Делян – водачът на българското въстание срещу Византия










[…] Месец борба и 10 операции: Лекари от Бургас спасиха паци… […]
[…] Месец борба и 10 операции: Лекари от Бургас спасиха паци… […]